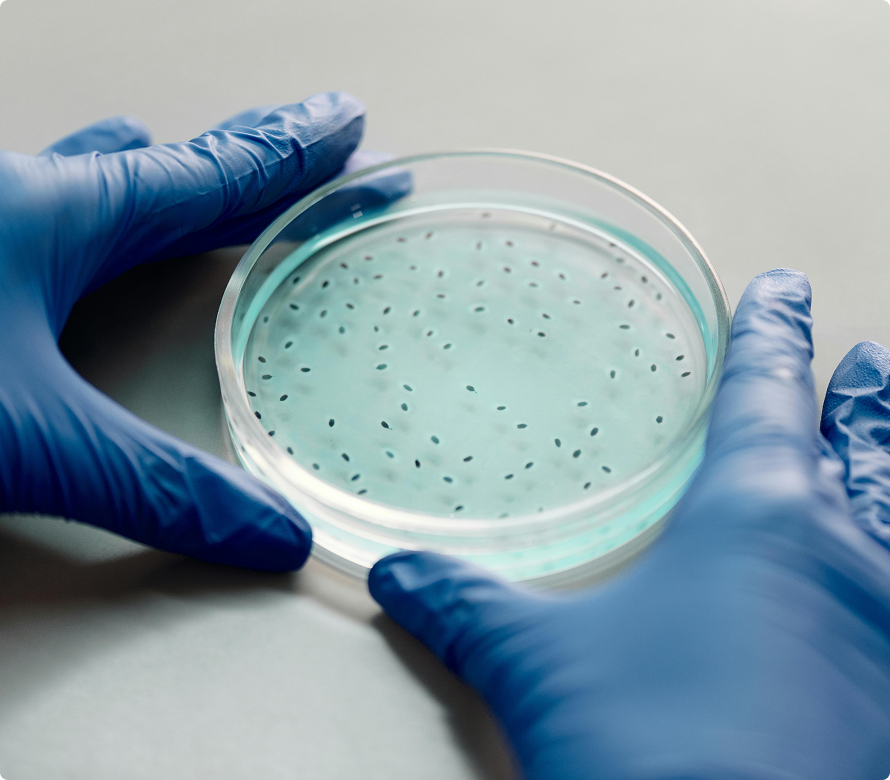
1. Microbial Concentration & Diversity

Organic Agriculture
Our amendments are designed to meet organic certification standards making them suitable for organic farming.

“Eden Earth has transformed my homestead. My soil is richer, and my crops are more abundant than ever!”— Emily R. • Homesteader


Soil microbes are the invisible workforce that feeds plants, builds structure, and drives nutrient cycling the foundation of every healthy ecosystem.
Improve nutrient absorption
Strengthen root systems
Rebuild soil structure
Increase drought resistance
Easc Earth's products are produced from a patented process that starts with cost conscientious byproducts from various manufacturers. Using a precise balance of bio-components harvested from a reduced-sodium artificial ocean water environment.
The process produces a greater variety and quantity of beneficial bacteria than what is available through soil microbe fixation alone and in other commonly and ancient biofertilizers.
The key innovation lies in the use of a specially formulated Aquatic system that redefines nutrient recycle while maintaining beneficial nutrients and microorganisms for plant growth.


Our amendments are designed to meet organic certification standards making them suitable for organic farming.

Demonstrated efficacy for vegetables (e.g., peppers, kale), fruits, and herbs

Can be used in both traditional and hydroculture settings.

Plant Clonings

Avoids sodium toxicity in plants, which is a common issue with ocean-derived and many other conventional fertilizers.

Contains beneficial bacteria and fungi that enhance nutrient uptake and soil health.

Utilizes fish waste in a closed-loop system, reducing environmental impact.

Proven superior growth and yield compared to commercially available fertilizers such as Miracle-Gro

Offers a novel approach to organic fertilizer production by integrating aquaculture and horticulture.

Scalable for large-scale farming, with potential applications in commercial greenhouse operations and specialty crop markets.

Reduces reliance on synthetic fertilizers and repurposes fish waste into valuable agricultural inputs.
Fresh fish excrement (from a system as from our patented process) contains a higher concentration and diversity of beneficial microbes than typical cow manure.
Here's Why
Soil microbes are microscopic organisms that live in the soil...



Our innovative process isn't just that it uses fish waste; it's that it leverages a highly controlled, engineered ecosystem to produce a specific type of fish waste that is:
Low in sodium (addressing the fatal flaw of seawater-based fertilizers).
Exceptionally rich in a targeted consortium of beneficial, aerobic microbes that are immediately available to enhance plant growth and soil health.
The advantages of fish skimmate produced by our patented process over cow manure generally extend to, and are even more pronounced when compared to, chicken manure.
Here’s Why:

Chicken manure is primarily a nutrient-rich soil amendment that needs time to become beneficial. In contrast, the patented fish waste is engineered to be an immediate, biologically-active, microbe-rich plant food. Its value proposition isn't just the nutrient content, but the delivery mechanism an active microbial consortium designed to maximize plant absorption and health.



Years of research show that boosting microbial life increases…
 Higher yields: Up to 25% increase in plant productivity
Higher yields: Up to 25% increase in plant productivity
 Stronger Roots: Deeper, denser root systems
Stronger Roots: Deeper, denser root systems
 Increased nutrient density: Plants retain moisture longer
Increased nutrient density: Plants retain moisture longer
 Better drought tolerance: Microbial activity improves absorption
Better drought tolerance: Microbial activity improves absorption


Eden Earth conducts extensive field trials on working farms, from small organic operations to large-scale agricultural systems. These real-world tests ensure our products perform under diverse conditions, delivering consistent results in yield, root growth, and soil health. Our trials involve precise measurements of plant performance and soil microbial activity, providing data-driven insights into the efficacy of our GeniGrow formula.

Our state-of-the-art laboratory analysis dives deep into the microbial composition of treated soils. Using advanced microscopy and DNA sequencing, we confirm the presence of specifically-chosen bacteria, fungi, and other microorganisms which are known participants in healthy soils. This ensures our inoculants are standardized from batch to batch and meet the highest standards of potency and effectiveness. This rigorous approach allows us to fine-tune our formulations for maximum impact on soil fertility and plant vitality.

We collaborate with leading agricultural research institutions to validate our findings and push the boundaries of soil science. These partnerships provide access to cutting-edge methodologies and independent verification of our products’ benefits. By combining academic rigor with practical application, Eden Earth ensures our solutions are grounded in the latest scientific advancements, inspiring confidence in growers seeking sustainable, high-performance soil solutions.

"Increased vegetable yield by 28% in one season using BioX treatment."
Healthy soils do more than grow crops—they protect ecosystems, reduce chemical dependency, and rebuild biodiversity.

Microbes restore organic matter, improving soil structure and water retention.

Microbial activity reduces the need for synthetic fertilizers and pesticides.

Healthier soils store more carbon and support a richer variety of life.

Your cart is currently empty
Shop now